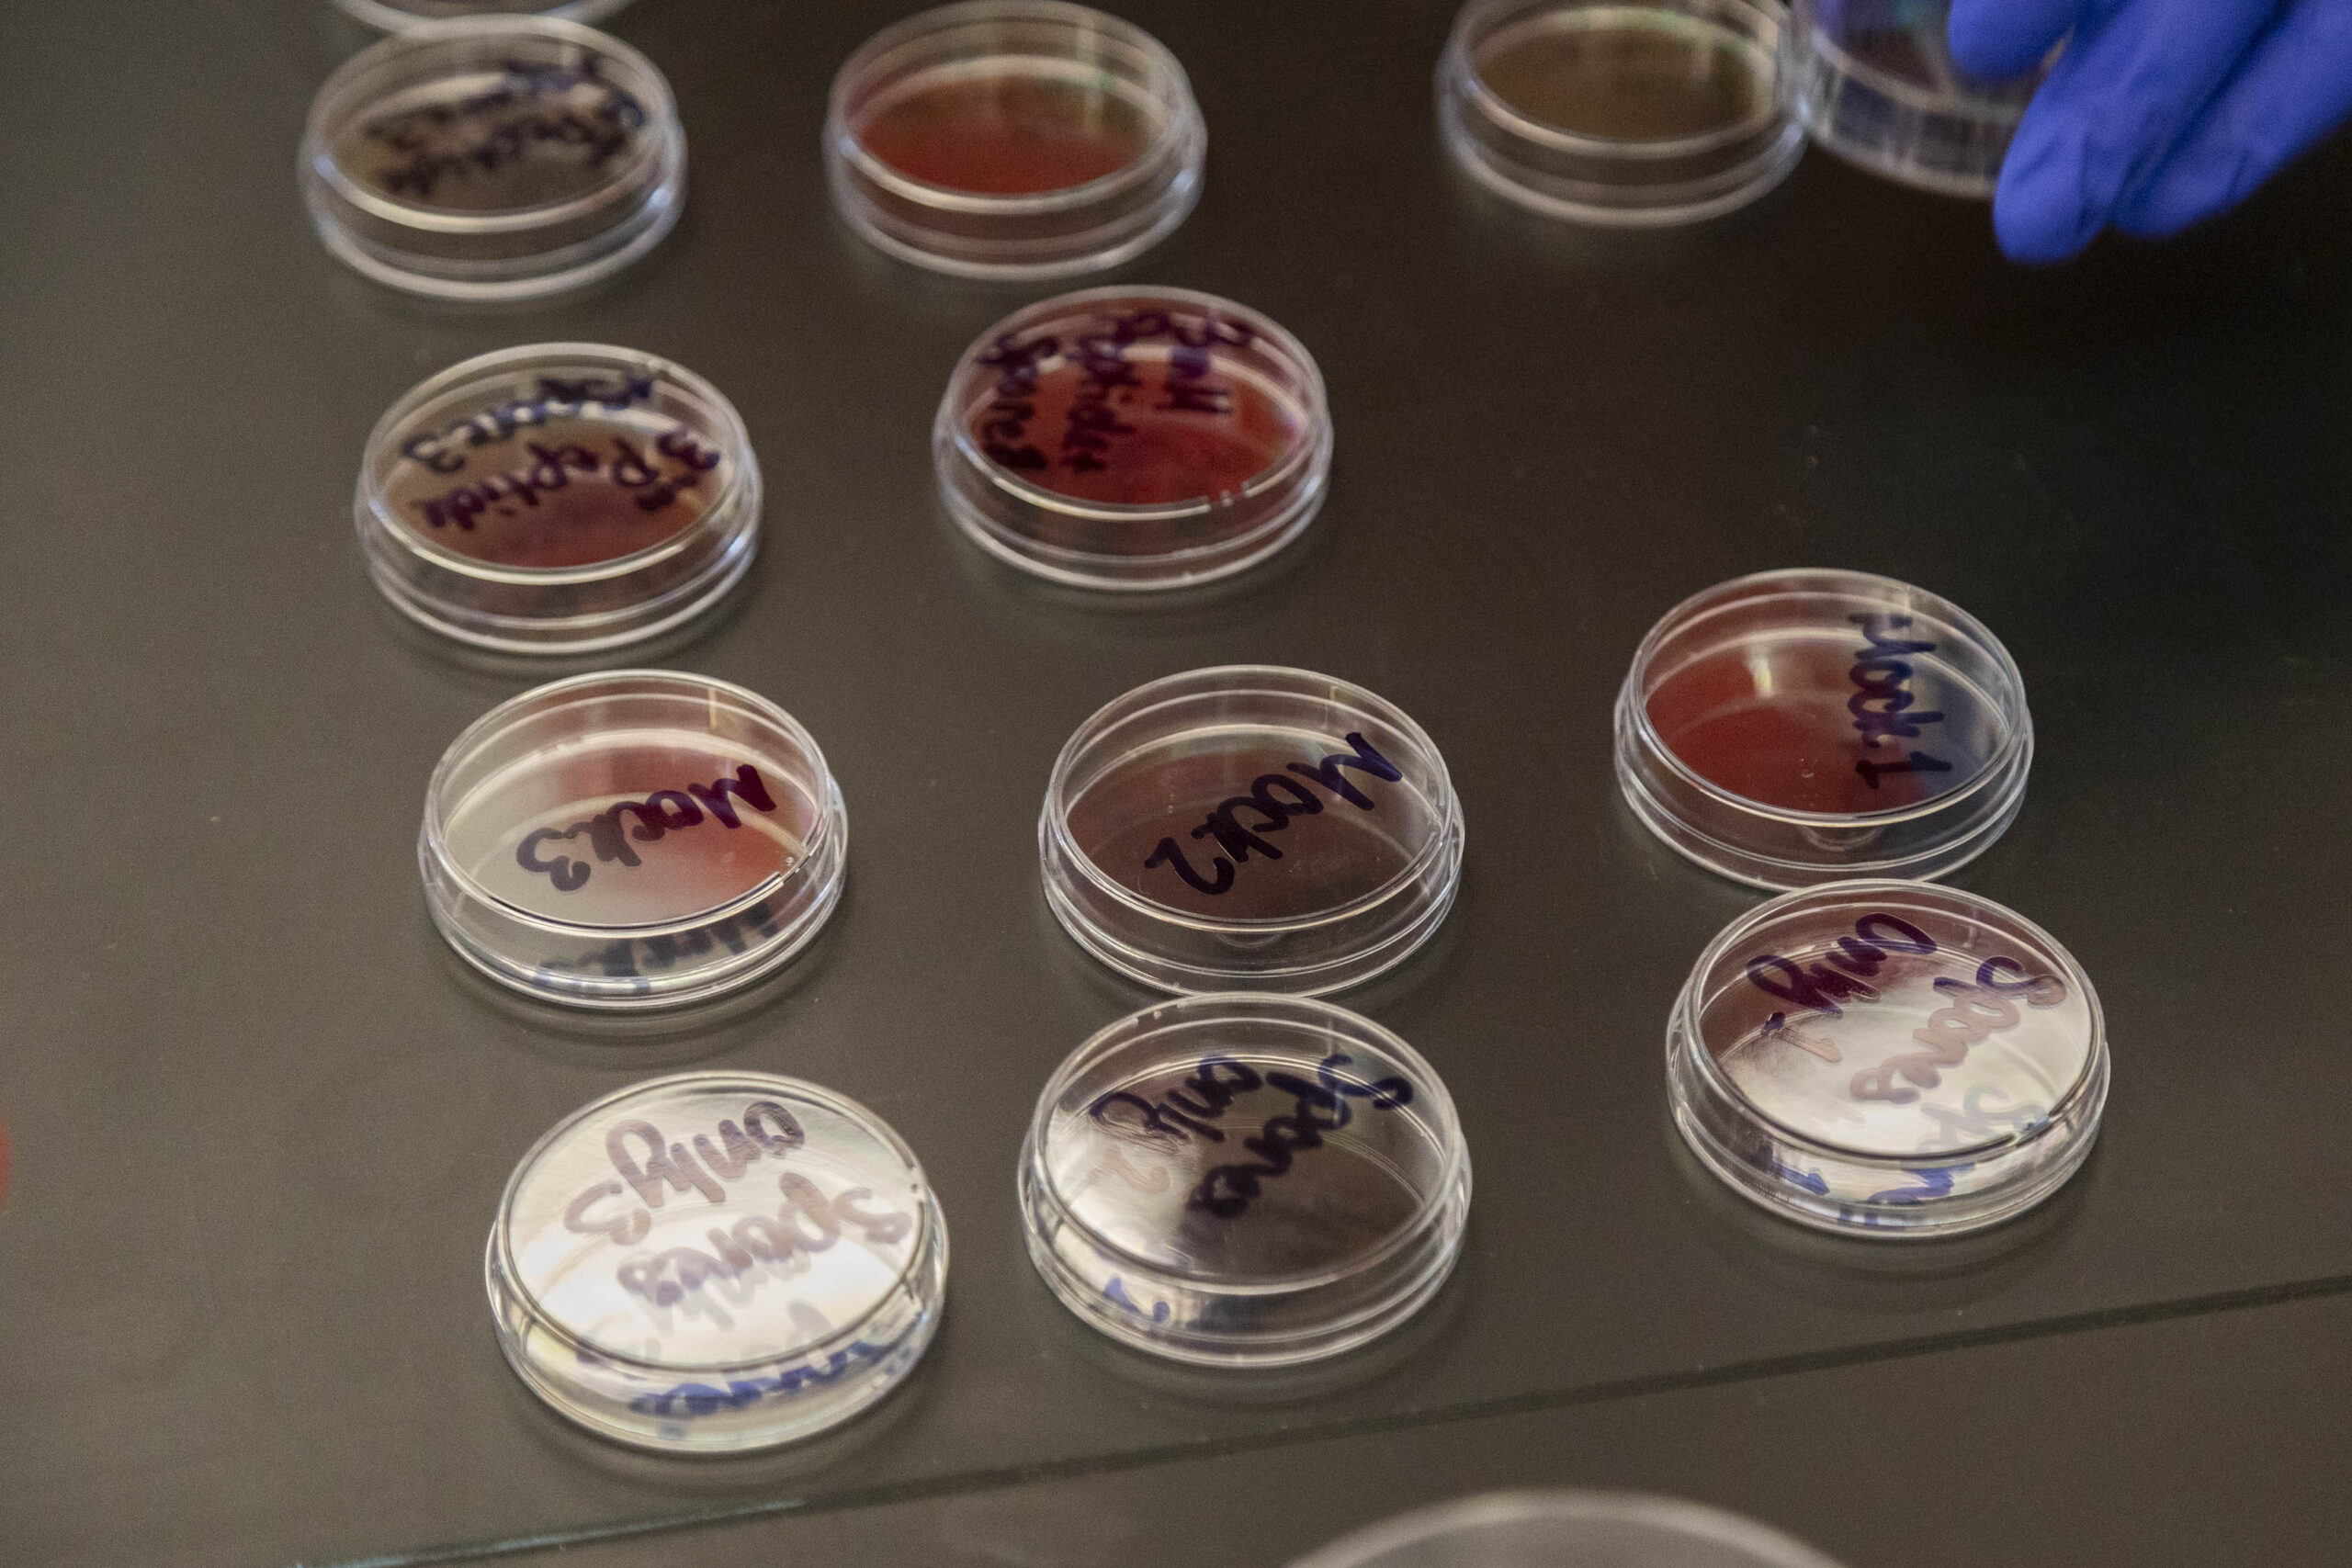

Juniors and seniors in our Biological Design course, taught by Laura Bradford, Upper School Science Teacher, recently conducted a project-based lab that studied how plants fight back against fungal spores. Chemical fungicides pose considerable health and environmental risks where fungi can develop resistance to chemicals and some chemicals can cause issues with human health. In this lab, students studied peptide-based biofungicides as alternatives to chemical fungicides. One student shared, “Antifungal peptides can be more selective and sensitive to only impact a particular fungus, and they eventually degrade into the environment.”
To prepare for their experiment that would test the effectiveness of a plant-derived peptide (a protein)as a defense against fungal plant infections, students first planted tomato seeds in a number of mini pots that were housed in our on-campus greenhouse. After placing the pots in an illumination incubator for two weeks, the seedlings began to germinate and were ready for the next step in the experiment: inoculation.
On Tuesday, April 7, students prepared the samples to inoculate by removing one leaf from each of the young tomato plants. On the leaf, they delicately placed fungal spores. Then, they treated the leaves with a Danforth Plant Science Center-provided peptide, which they hoped would act as an antifungal agent. Their goal was to test which peptide concentration (3, 6, 12 µM or micromolars) gave the best protection.
There were two methods for applying the fungal spores and the anti-fungal peptides: the drop inoculation assay or the spray assay. The drop inoculation assay involved counting out sterile petri-dishes, laying out the clean petri dishes on the lab bench, placing the youngest leaves from a seedling on the petri dishes, and then using a pipette to drop different concentrations of peptides onto each leaf. Then, they used a pipette to apply the fungal spores on the leaves at exactly the same spot where the peptides were applied. Next, they made weather shield boxes from Ziploc bags with wet paper towels to provide humidity. Following, the boxes were stored for 60 hours of incubation as students made observations and collected data on the leaves. Lesions are visible to the naked eye after 24-36 hours, so students started collecting data after about two days of incubation.
On Thursday, April 9, the juniors and seniors observed their samples as they looked for fungal lesions. They took pictures of their plants. The pictures, along with a ruler, allowed them to use a computer to measure the size of the lesions for their data table. To calculate the lesion sizes, they used a program called ImageJ, which is an open-source image processing program for multidimensional image data with a focus on scientific imaging. They calculated the relative lesion size in the presence of the varying concentrations of peptides incomparison to the control.
Students learned that fungal infections of plants manifest in different forms or symptoms such as lesions, necrotic spots, and black smuts. In this lab, students examined the antifungal defense mechanisms of the antifungal peptides applied to the tomato seedlings infected by the fungal pathogen Botrytis cinerea. Botrytis cinerea is an important fungal pathogen that causes grey mold disease in multiple crop plants. Their hope was to determine which concentration of the antifungal peptide completely inhibits fungal lesion formation on the tomato seedling leaves.
After collecting the data that they organized into an Excel document, students created graphs to see whether peptides can protect plant leaves from Botrytis cinerea infection (see example 1 and example 2). They shared this final data back with the Shah Lab of the Danforth Plant Science Center. A student shared of the results of the lab: “Interestingly, the best results came from the 3 µM (micromolar) concentrations of peptide or from 6 µM. Most students would have predicted that the stronger concentration, like 12 µM, would be the most effective, but that isn’t what any of the groups saw in their data.”
In conclusion, the lower concentrations of peptides did indeed protect the plant leaves from the B. cinerea infection. Becca Frazier ’26 summarized, “The average lesion size increased as the peptide concentration increased.” Some students found differing results, but overall, they could support with their data that the peptide works to reduce the size of fungal lesions.
Earlier in the semester, this class visited the Danforth Plant Science Center. Ms. Bradford shared, “What really struck us was that one of the researchers from the lab who is working on this very project, Dr. Godwin James, took time out of his schedule to meet our class after our tour. He was able to summarize what we were working on and answered student questions. He was really impressed with the depth of questions our students asked and their understanding of the science behind their work. Dr. James was also able to supply us with a sample of both the fungal spores and the peptides that they work with, so my students were able to run a version of the experiments their lab has been doing.”
Thank you, biological design scientists, for your hard work on this lab. How very interesting to learn about another more environmentally friendly way for plants to fight back in a lab that is also conducted by professional plant scientists! Great work, Ram scientists!